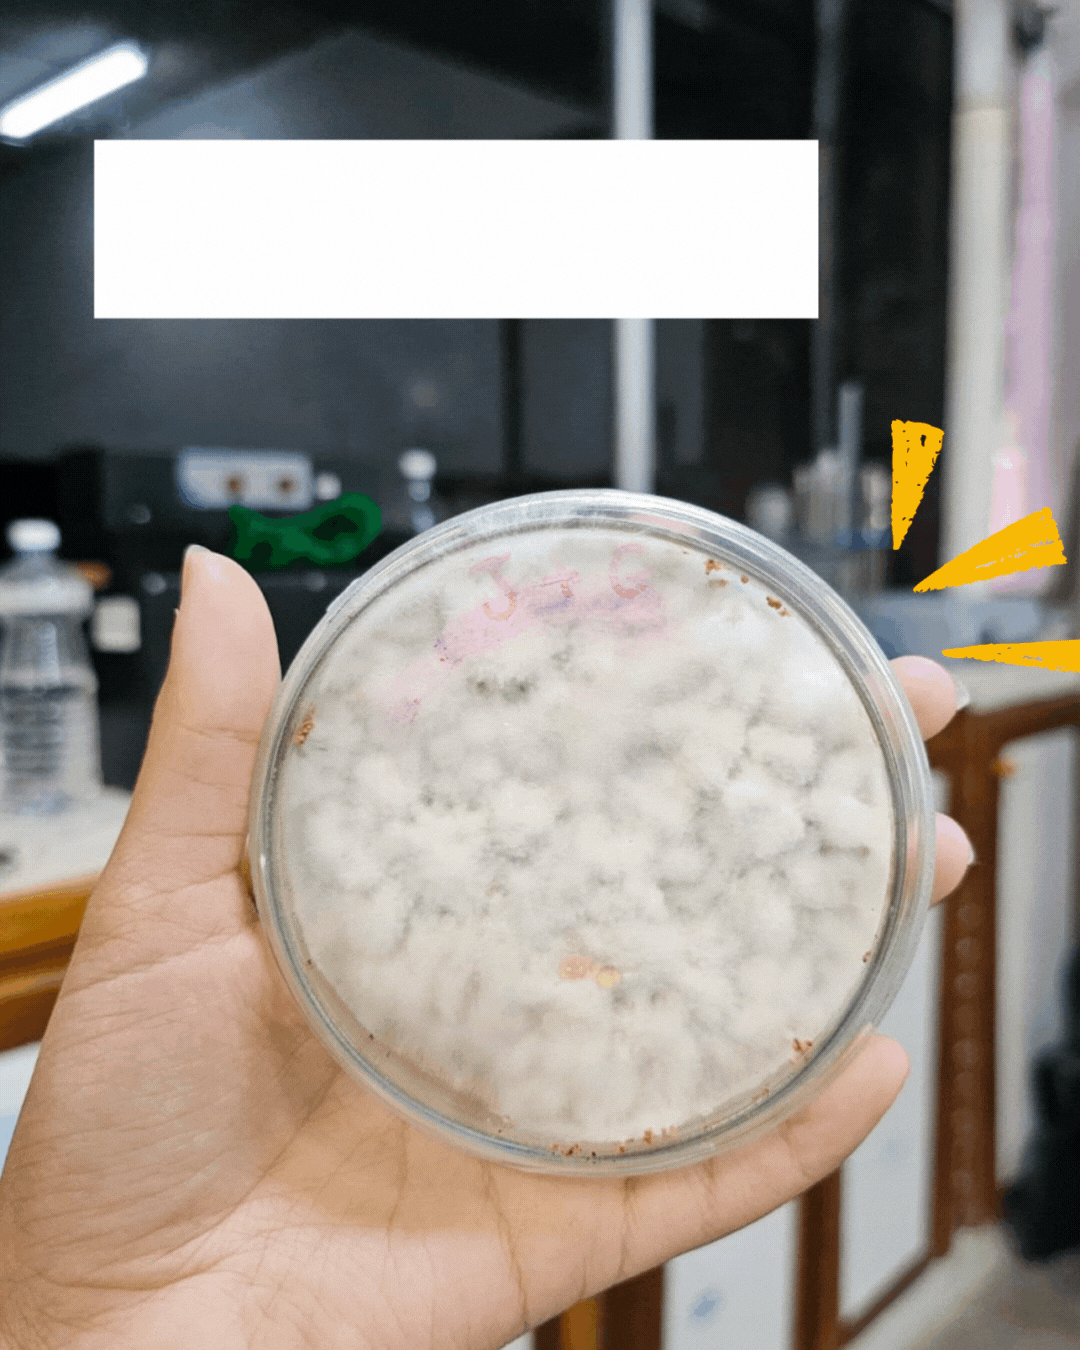

- mfranco6
- 17 de set.
- 1 min de leitura
Esta semana, o Dr. Igor Sampaio, juntamente com as doutorandas Isabela de Moura e Taíse Ribeiro, representaram o Laboratório de Biotransformação e Biocatálise Orgânica (UESC) no XIII Simposio Nacional de Ingeniería Química y Bioquímica Aplicada, realizado em Saltillo, México.
Desde agosto, esses pesquisadores participam de uma instância de colaboração entre o Labiocat e o Biorefinery Group da Universidad Autónoma de Coahuila (projeto financiado pelo CNPq) fortalecendo laços científicos e ampliando oportunidades de pesquisa conjunta.
Durante o evento, foram apresentados três pôsteres abordando temáticas relevantes, como: valorização de resíduos lignocelulósicos, processamento de águas residuais têxteis, produção de biomassa de microalgas utilizando frações líquidas do processamento de resíduos têxteis.
Destaca-se que o pôster apresentado pelo Dr. Igor Sampaio recebeu um prêmio de reconhecimento como melhor apresentação na área de bioprocessos, em virtude do trabalho com microalgas cultivadas em água residual têxtil processada. Além disso, o Dr. Igor também realizou uma apresentação oral sobre valorização de águas residuais têxteis, reforçando a importância dessa linha de pesquisa para o desenvolvimento sustentável.
O evento foi uma oportunidade valiosa para troca de experiências, networking com novos pesquisadores e aprofundamento em diferentes linhas de pesquisa.